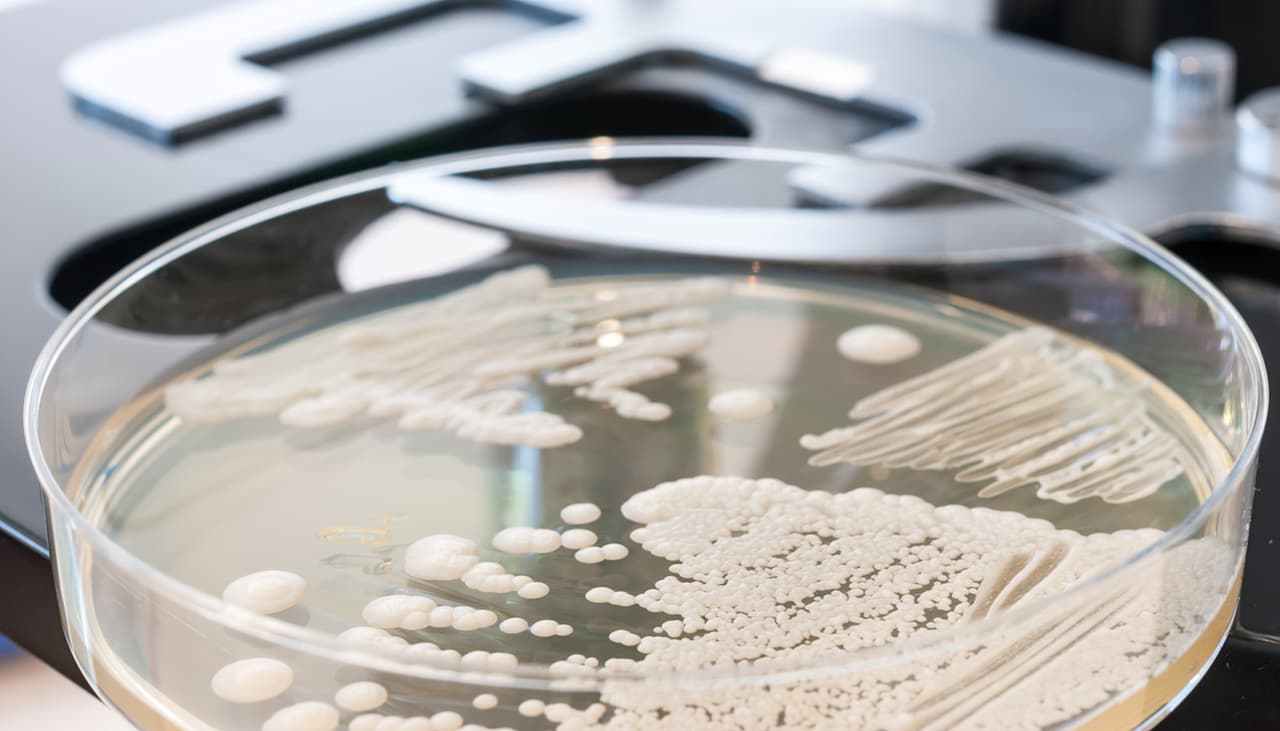

La candidiasis es un padecimiento muy común en las mujeres y se puede presentar desde que son pequeñas. Es provocada por hongos y una de sus principales causas es la baja inmunidad, así como el uso de antibióticos y corticosteroides.
Las niñas pequeñas pueden sufrir candidiasis debido a un descuido muy común ¡evítalo!

Sus síntomas más habituales son picor, ardor genital, enrojecimiento en la vulva, molestias al orinar y flujo vaginal de aspecto blanquecino, explica el Hospital Victoria Eugenia.

De acuerdo con la organización Cigna, si recibe el tratamiento adecuado y en el momento justo, es probable que la infección desaparezca sin complicaciones.
No obstante, cuando es ignorada puede presentar síntomas mucho más graves, como dolor intenso y sangrado.

Candidiasis en niñas
En el caso de las niñas, el motivo central de una candidiasis puede ser la falta de higiene en la zona. Cuando las pequeñas empiezan a ir al baño, se vuelven más independientes e incluso les agrada limpiarse sin recibir ayuda.
Es en este momento cuando el padre y la madre necesitan enseñarle cómo asearse correctamente. La limpieza debe realizarse de adelante hacia atrás (es decir, de la vagina hasta el ano) y no al revés.
Si los padres limpian el área de atrás hacia adelante, arrastrarán las bacterias de la región del ano hasta la vagina. Esto aumenta las posibilidades de que la niña desarrolle esta enfermedad.

La mejor recomendación de la ginecóloga ALyk Vargas, de la Clinica Ellas, es realizar una higiene óptima en la zona, evitando que la proliferación de hongos provoquen un desequilibrio en la flora vaginal y causen esta temible afección.

La importancia de los hábitos de limpieza
El sitio web especializado Mom Junction explica que este aprendizaje funciona como una base para que tu pequeña comience a responsabilizarse por su cuidado personal.
Enseñarle la forma correcta de limpiar sus partes íntimas a una edad temprana, la hará más consciente de la importancia de tener buenos hábitos de limpieza y servirá como antecedente para mostrarle nuevos conocimientos.

Durante todo este proceso, es necesario que le expliques las consecuencias de hacerlo incorrectamente.
Así conocerá los riesgos de estar expuesta a gérmenes y bacterias, y pondrá más atención en los procesos que se relacionan con la higiene, explica Health Direct.

Por otro lado, la Academia Americana de Pediatría subraya que felicitar a la pequeñita por esta enseñanza aumenta su confianza y autoestima, puesto que los comentarios positivos le demostrarán que es capaz de aprender nuevas destrezas y cumplir metas.

Al permitir que se desarrolle a su propio ritmo y sin emitir juicios, le estás brindando las herramientas necesarias para que sea más independiente y tenga un mayor nivel de confianza en sí misma.

En muchos sentidos, el éxito de este aprendizaje depende de la paciencia y la atención que le brindes a tu hija. Trata de ir paso a paso y asegúrate de que entienda la importancia de limpiarse correctamente.
Finalmente, esto reforzará sus lazos de comunicación y marcará el inicio de una nueva etapa que estará llena de enseñanzas para ti y tu pequeña.

Y tú ¿cómo le enseñas hábitos de limpieza a tus hijos? Escribe tus mejores tips en los comentarios.
mini:
¡Hey, no te vayas! Pensamos que te gustaría leer esto:
Original Author: Mariana Riscala Original Author URL: https://www.vix.com/pt/users/mariana-riscala
Original ID value: 555142
Original Site: pt
Original URL: https://www.vix.com/pt/maes-e-bebes/555142/meninas-podem-ter-candidiase-mesmo-ainda-criancas-gracas-a-um-erro-muito-comum










